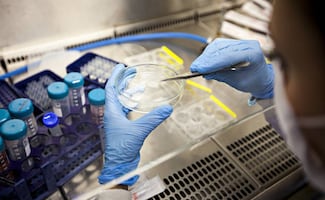
Trasplante de células madre logra curación de VIH; es el resultado de más de una década de investigación internacional

Más Información

Reportan desaparición del alcalde de Taxco, Guerrero; caso ocurre tras privación de la libertad de su padre
Trasplante de células madre logra curación de VIH; es el resultado de más de una década de investigación internacional
[Publicidad]














